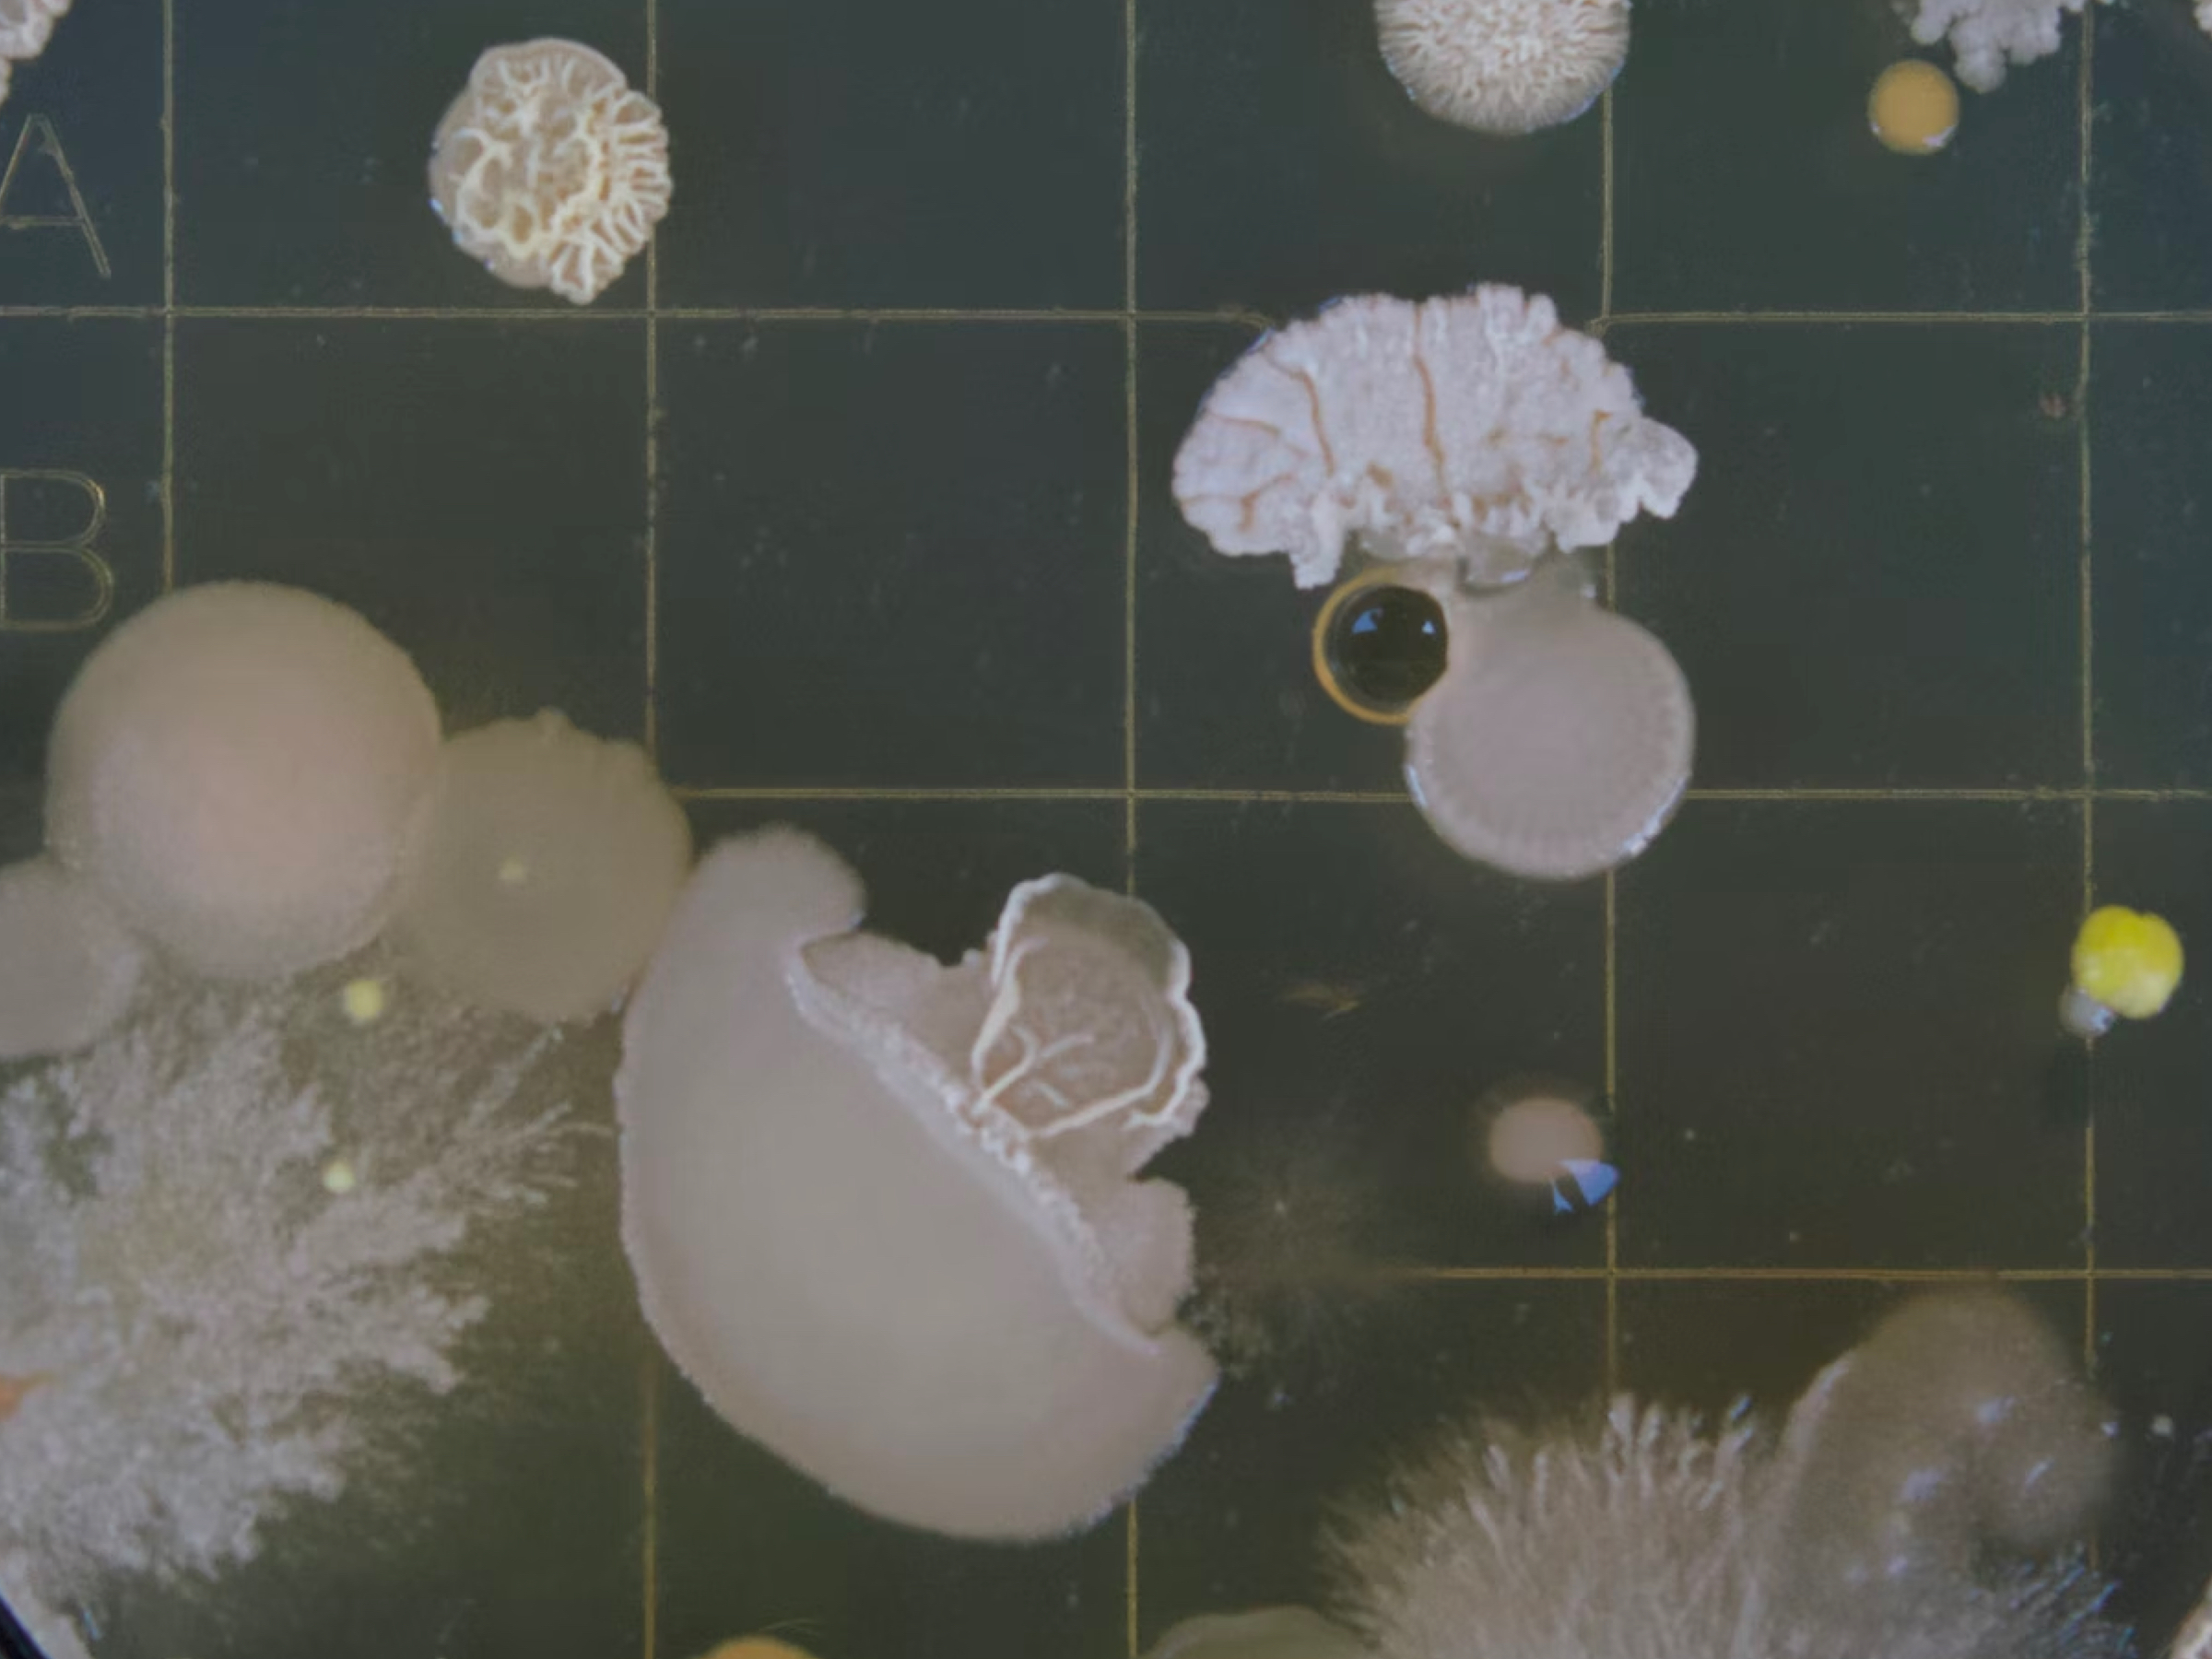

Stotine naučnica i naučnika, sadašnjih i budućih, udružilo je snage u organizaciji najveće naučne zabave u regionu – Festivala nauke, koji će se održati od 4. do 6. maja u svom prepoznatljivom formatu, na Beogradskom sajmu u Halama 3 i 3a, na više od 6.000 m2.
Uzbudljivi eksperimenti koji razbijaju mitove, postavke koje će vas naterati da preispitate brojne (pseudo)istine, druženja koja će vam otkriti zabavno lice nauke. I sve tu uz koračanje kroz vreme, skakanje sa meridijana na meridijan, pa čak i putovanje daleko izvan granica naše planete.
Biološki fakultet Univerziteta u Beogradu za Festival nauke priprema poseban program pod nazivom „Snežne bakterije i nervni impulsi“. Prema njihovim rečima, ovo je pravi kutak za prirodne fenomene koji deluju neverovatno, ali su više nego istiniti. Povešće nas na putovanje kroz različita carstva živog sveta, gde ćemo imati prilike da upoznamo neobične i golim okom nevidljive organizme. O tome smo razgovarali sa Dr Miloradom Dragićem, doktorom bioloških nauka i asistentom sa doktoratom Biološkog fakulteta Univerziteta u Beogradu.
Kako ste se odlučili za program koji predstavljate na Festivalu nauke i šta izdvajate kao najzanimljivije?
Postavka Biološkog fakulteta na ovogodišnjem Festivalu nauke predstavlja samo jedan deo obrazovno-naučnog programa, koji nudimo našim studentima kao i deo istraživanja kojima se bavi naš fakultet. Biološki fakultet ove godine proslavlja veliki jubilej, 170 godina od začetka biologije u Srbiji, te je ovo idealna prilika da se predstavimo sa svime što Biološki fakultet, kao jedna od najstarijih visokoobrazovnih institucija u zemlji može da ponudi. Postavka će biti interaktivna, a posetioci će imati priliku da vide kako bakterije mogu da zamrznu vodu i da nahrane biljku mesožderku. Konačno, svi zainteresovani posetioci imaće priliku da vide i „zavire“ u naše srce, pluća i mozak i da izmere svoju moždanu aktivnost, i još mnogo toga drugog.
Zbog čega je važno da deca i mladi vide vašu postavku? Kakvo znanje će oni poneti kući nakon festivala?
Biologija je nauka 21. veka i veoma je važno, naročito u današnjim okolnostima gde su ekocid, izumiranje biljnih i životinjskih vrsta kao i porast učestalosti različitih bolesti čoveka tužna svakodnevica, da se deca i mladi upoznaju sa biologijom kroz interaktivni pristup, i razumeju značaj bavljenja ovom naukom i šta sve ona podrazumeva i može da pruži. Biologija je fundament za razumevanje raznih procesa i mnogih drugih izvedenih disciplina, praktično živog sveta u celini. Posetioci će se upoznati sa vrstama za koje većina ni ne zna da postoje, poput bakterija koje mogu da žive u „večnom ledu“, kao i da saznaju kako funkcionišu srce, pluća i mozak koji rade neprestano, bez uticaja naše volje, a o čemu često ni ne razmišljamo.
Koji je to idealan balans između “zabavnog” i “ozbiljnog” kada govorimo o načinu na koji predstavljamo nauku, i kako ste vi pristupili ovom pitanju?
Predstavljanje nauke je veoma odgovoran zadatak, naročito u vremenu kada smo okruženi brojnim (dez)informacijama. Naša glavna ideja je da upravo to „ozbiljno“ prikažemo posetiocima na zabavan način, postupno, kroz korake, tako da ih „suvoparni“ detalji ne opterećuju, a da na kraju dobiju ideju o tome kako nešto funkcioniše kroz interaktivni pristup i neposredno iskustvo.
Kako vidite značaj samog Festivala nauke u širem smislu, u kontekstu saradnje s obrazovnim sistemom i/ili privredom?
Festival nauke je veoma značajna manifestacija jer na jednom mestu okuplja mnogo različitih nauka i disciplina i stvara čvorište interdisciplinarnosti, bez čega je današnja nauka nezamisliva! Pored toga, festival može da bude i kreator mnogih ideja, gde nastavnici i profesori osnovnih i srednjih škola mogu da vide različite eksperimente koje mogu da prenesu u učionice i približe učenicima nauku. Takođe, kada se na jednom mestu nađu naučnici iz raznih oblasti, rađaju se nove ideje i saradnje koje mogu da doprinesu pomeranju „kruga znanja“ a potencijalno i razvoju nekih novih proizvoda koje, potencijalno, mogu naći mesto i na tržištu.
Tema ovogodišnjeg Festivala nauke je NOVO DOBA koje nam je ubrzano došlo zahvaljujući svetskoj pandemiji. Festival ovim sloganom želi da ukaže na promene koje su nam se dogodile tokom godina izolacije – na percepciju sveta oko nas, a najviše nauke i naučnih dostignuća. Više o programu festivala pročitajte na linku: https://festivalnauke.rs/
